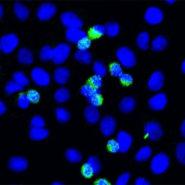

De partout dans le monde, des alarmes remontent en provenance des oncologues qui, depuis l’épidémie de Covid n’ont jamais vu autant de cancers, des cancers fulgurants et des cancers en rémission qui se réactivent.
Je partage avec vous aujourd’hui une communication du professeur Ryan Cole, pathologiste, qui concerne les conséquences de la vaccination anti-covid et plus particulièrement de la protéine Spike sur les cancers. Il se réfère à un article paru dans le British Medical Journal.
Avant la vidéo, voici une courte synthèse de la communication :
La conclusion de l’article est assez inquiétante à savoir que le vaccin induit une reprogrammation fonctionnelle complexe des réponses immunitaires innées.
En clair, le vaccin réduit notre réponse immunitaire naturelle aux attaques de virus et aussi à l’attaque des cancers.
On a pu observer, après la vaccination, la réactivation de la varicelle-zona et d’autres virus.
Cela rejoint aussi toutes ces informations en provenance des oncologues du monde entier. Ryan Cole cite l’exemple de ce médecin de famille exerçant en Irlande depuis 40 ans. Il connait parfaitement ses patients, certains vaccinés, certains non vaccinés. Il a observé parmi les vaccinés et a énuméré le nombre de cancers qu’il a vu en 6 semaines et qu’il n’avait jamais vu en 40 ans de carrière !
Selon l’épidémiologiste de renommée mondiale, Harvez Risch, on voit les effets d’une injection ou d’une thérapie seulement après 5 à dix ans !
Il est clair que nous avons quelque chose que nous n’avons jamais vu auparavant et qui supprime soudainement l’un des récepteurs qui est hautement responsable de la maitrise des cancers !
Voici la vidéo complète :
De tout cela, vous n’entendrez pas parler dans les médias généralistes !




Suivre @ChrisBalboa78
Une réponse à “Vers une épidémie … de cancers ?”
Attention, Christian, vous allez une nouvelle fois vous faire taxer de « complotisme fascistoïde »..